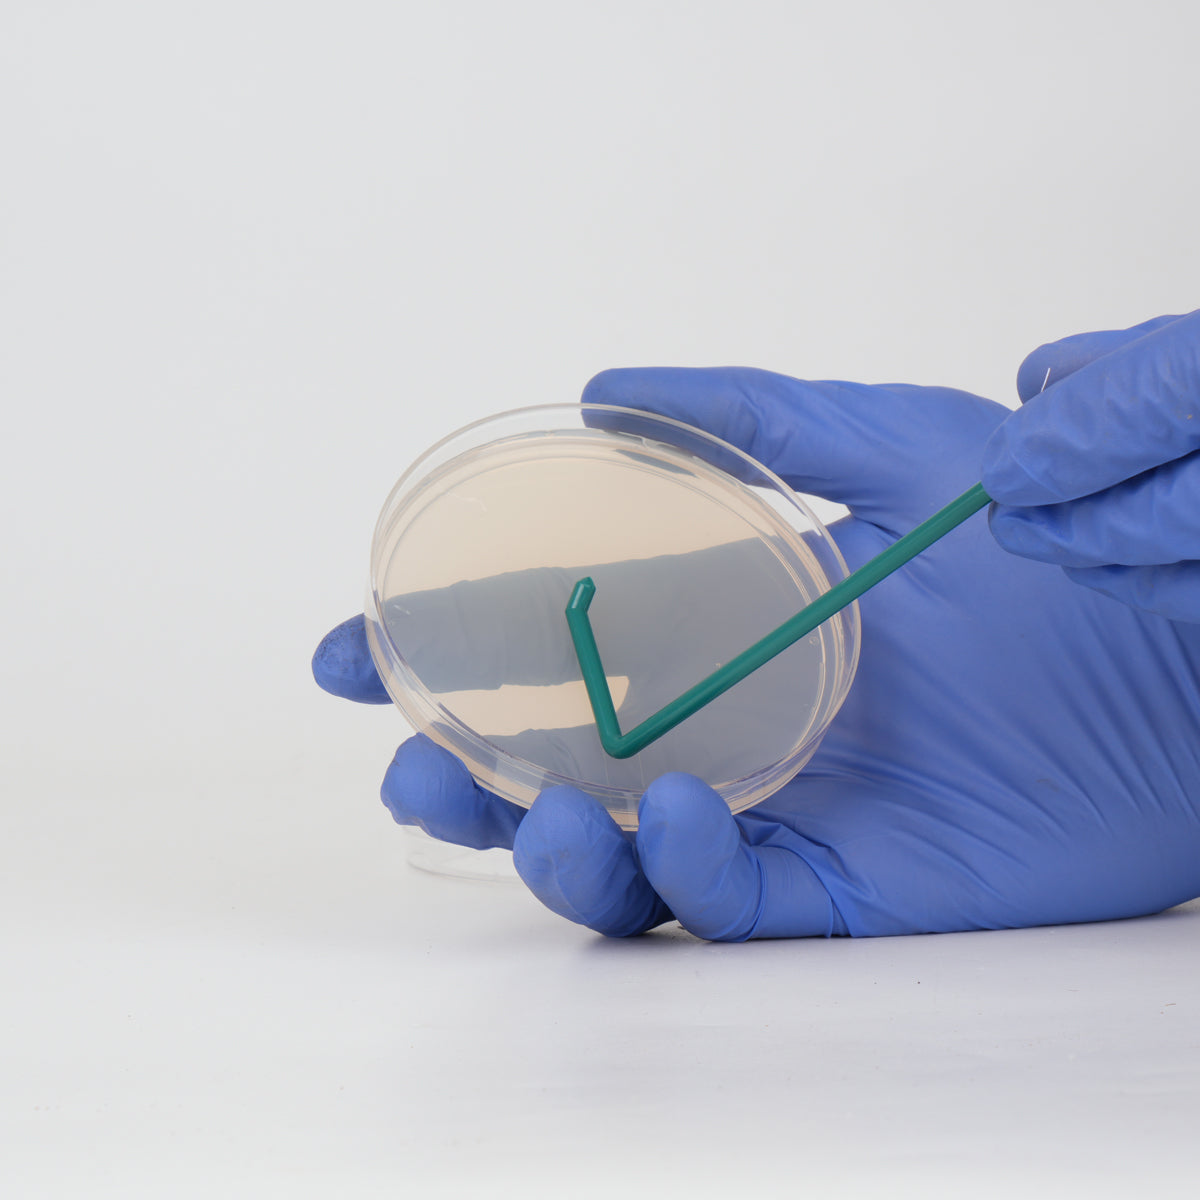

L-Shape Plate Spreaders (Sterile Pack of 10)
Lead Time
1-3 working days• Expected to ship: June 19 - June 23, 2026
Plate spreaders are used to spread liquid culture or spore solution across your agar surface. Perfect to distribute drops from your spore syringe and ensure even distribution.
Pack of 10 spreaders (Can be resealed using bag sealer)
Your payment information is processed securely. We do not store credit card details nor have access to your credit card information.